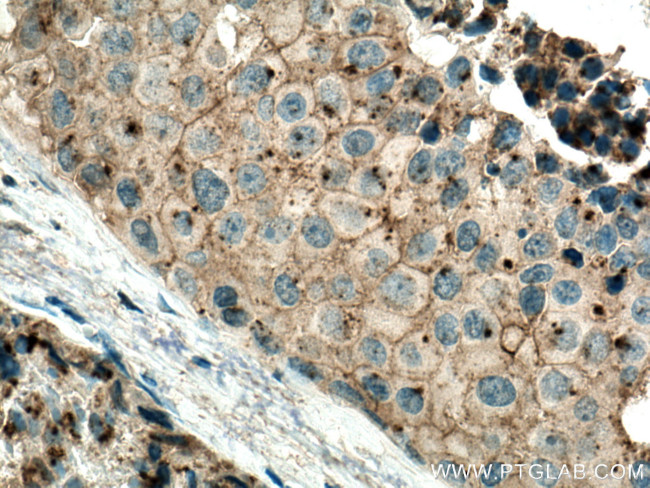
Flotillin 2 Antibody in Immunohistochemistry (Paraffin) (IHC (P))
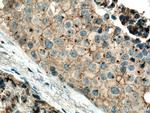
Flotillin 2 Antibody in Immunohistochemistry (Paraffin) (IHC (P))

Search
Proteintech
Flotillin 2 Monoclonal Antibody (1E11G12)
{{$productOrderCtrl.translations['antibody.pdp.commerceCard.promotion.promotions']}}
{{$productOrderCtrl.translations['antibody.pdp.commerceCard.promotion.viewpromo']}}
{{$productOrderCtrl.translations['antibody.pdp.commerceCard.promotion.promocode']}}: {{promo.promoCode}} {{promo.promoTitle}} {{promo.promoDescription}}. {{$productOrderCtrl.translations['antibody.pdp.commerceCard.promotion.learnmore']}}
产品信息
66881-1-IG
种属反应
宿主/亚型
分类
类型
克隆号
抗原
偶联物
形式
浓度
纯化类型
保存液
内含物
保存条件
运输条件
产品详细信息
Aliquoting is unnecessary for -20°C storage.
靶标信息
Caveolae are small domains on the inner cell membrane involved in vesicular trafficking and signal transduction. This gene encodes a caveolae-associated, integral membrane protein, which is thought to function in neuronal signaling.
仅用于科研。不用于诊断过程。未经明确授权不得转售。
生物信息学
蛋白别名: Epidermal surface antigen; ESA; Flotillin 2 (epidermal surface antigen 1); Flotillin-2; Membrane component chromosome 17 surface marker 1; Membrane component chromosome 17 surface marker 1 homolog; membrane component, chromosome 17, surface marker 1 (35kD protein identified by monoclonal antibody ECS-1); OTTHUMP00000163513; REG-1; Reggie-1; reggie1-1
基因别名: AI573412; ECS-1; ECS1; ESA; ESA1; FLOT2; M17S1; Reg1; reggie-2
UniProt ID: (Human) Q14254, (Mouse) Q60634, (Rat) Q9Z2S9
Entrez Gene ID: (Rabbit) 100344093, (Human) 2319, (Pig) 100518752, (Mouse) 14252, (Rat) 83764